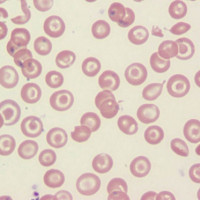

Železo je minerál, který je již dlouho známo, že je důležité v průběhu těhotenství. Je nezbytné vytvořit hemoglobin, molekulu, která přenáší kyslík do buněk a tkání těla. Během těhotenství se objem krve zvyšuje o 30%, což znamená, že ženy potřebují více železa, aby vytvořily více hemoglobinu. To platí zejména během 2. a 3. trimestru.,
pokud žena vstoupí do těhotenství bez dostatečných zásob železa, stane se anemickou v pozdějších fázích těhotenství. Proto se doporučená denní dávka (RDA) pro železo pohybuje od 18 mg/d u netehotných žen do 27 mg/d u těhotných žen.
na tomto základě bychom mohli mít podezření, že je nezbytné, aby všechny ženy doplňovaly železo během těhotenství. A to je přesně to, co doporučují tradiční zdravotnické úřady.
s tímto přístupem však existují určité problémy.,
za Prvé, je důležité pochopit, že je normální, že hladiny hemoglobinu na podzim během těhotenství. Jak ukazuje níže uvedený graf, normální hladiny hemoglobinu u netehotných žen se pohybují od 12 do 16 g / dl. U těhotných žen @28 týdnů tento rozsah klesá z 10-14 g / dl. Jedná se o normální fyziologickou změnu během těhotenství a neznamená problém.
hladiny hemoglobinu se vrátí do netehotného rozmezí v týdnech po narození., Kromě toho jsou nejlepší výsledky porodu spojeny s hladinami hemoglobinu na dolním konci rozsahu 10-14 g/dL.
To vysvětluje, proč studie ukazují, že suplementace rutiny železa (bez doprovodných značek & příznaky anémie) během těhotenství je nejen prospěšné, ale potenciálně škodlivé.
Železo suplementace má zvýšit hemoglobin & hladiny železa v krvi, ale nemá žádný zjistitelný vliv na důležité klinické výsledky jako pre-termín porodu, porodní váhu a APGAR při narození.,
suplementace železem může být také zodpovědná za nežádoucí účinky, jako je snížená absorpce jiných minerálů a gastrointestinální příznaky, jako je plyn, nadýmání a zácpa.
samozřejmě, že ženy, které vykazují známky a příznaky anémie (únava, dušnost, bledá kůže, studené ruce & nohy, atd.) by měl být hodnocen lékařem a může potřebovat doplnění železa.
Leave a Reply